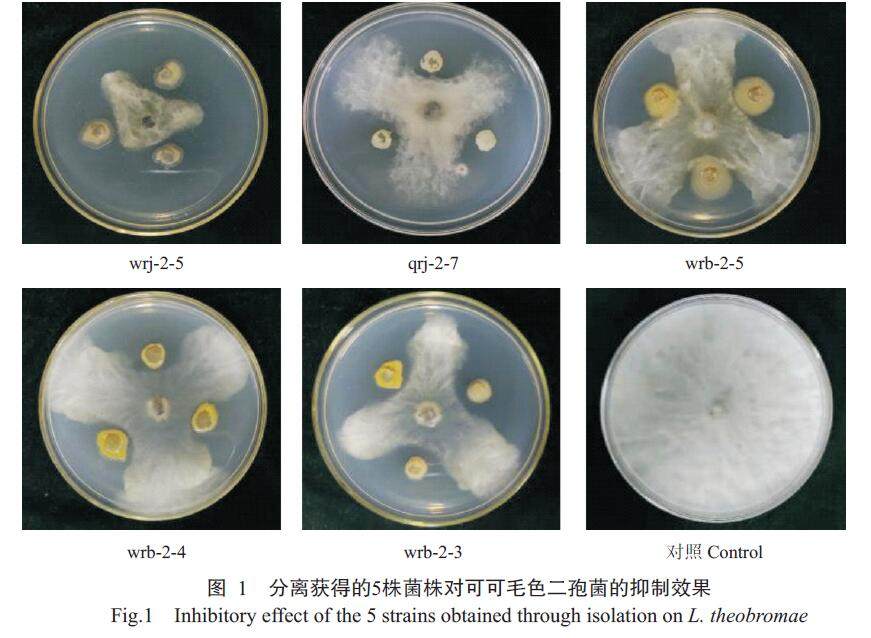

可可毛色二孢拮抗菌的鉴定及发酵条件优化
打开文本图片集
摘要:【目的】筛选对可可毛色二孢菌(Lasiodiplodia theobromae)具有拮抗作用的生防菌株,为由可可毛色二孢菌引起的槟榔根腐病的生物防治提供菌种资源及指导。【方法】以海南发病槟榔园健康槟榔根组织及根际土壤为试验材料,采用组织匀浆法和平板稀释梯度培养法分别分离槟榔根内生细菌及根际土壤中的细菌,应用平板对峙法筛选出对可可毛色二孢菌具有拮抗作用的菌株;通过平板对峙法测定拮抗菌株菌液对3种槟榔根部病害病原真菌尖孢镰刀菌(Fusarium oxysporum)、奇异根串珠霉菌(Thielaviopsis paradoxa)和可可毛色二孢菌的抑制作用;通过形态学观察、生理生化测定和16S rDNA序列分析对拮抗菌株进行鉴定;采用盆栽试验初步验证拮抗菌株对由可可毛色二孢菌引起的槟榔根腐病的防治效果;采用单因素变化试验等筛选拮抗菌株的最佳发酵条件。(剩余24469字)